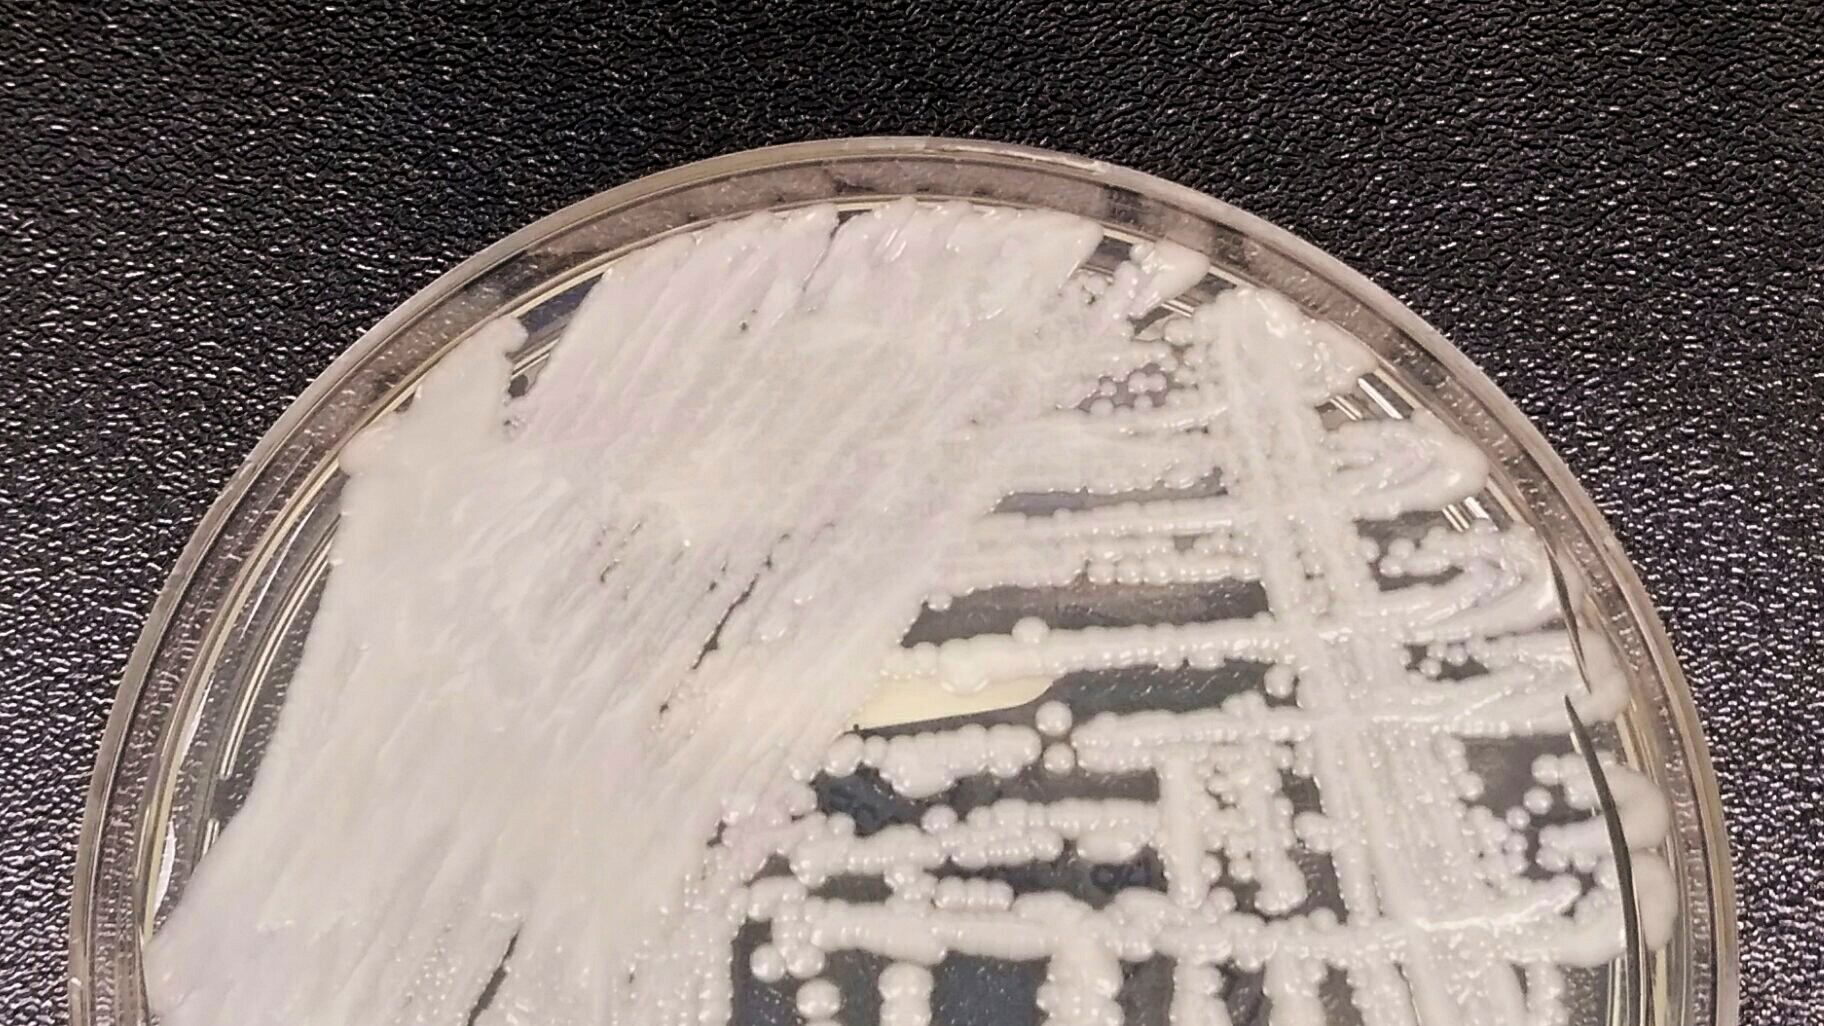

NUEVA YORK (AP) — Los casos en Estados Unidos de un peligroso hongo se triplicaron en los últimos tres años y más de la mitad de los estados ya han reportado casos, según un nuevo estudio.
Es probable que la pandemia del COVID-19 impulsó parte del aumento, según un ensayo de investigadores de los Centros para el Control y la Prevención de Enfermedades (CDC, por sus siglas en inglés) publicado el lunes en Annals of Internal Medicine. Los trabajadores de hospitales estaban presionados con los pacientes del coronavirus, y probablemente eso desvió su atención de desinfectar otro tipo de gérmenes, señalaron.
El hongo, Candida auris, es una especie de levadura que no suele ser dañina en personas saludables, pero puede representar un riesgo mortal para pacientes delicados en hospitales y asilos de ancianos. Se propaga fácilmente y puede causar infecciones en heridas, oídos y el flujo sanguíneo. Algunas cepas son las llamadas superbacterias que son resistentes a los tres tipos de antibióticos usados para tratar infecciones micóticas.
Se identificó por primera vez en Japón en 2009 y cada vez se ve más en otros países. El primer caso en Estados Unidos fue en 2013, pero no se reportó hasta 2016. Ese año, funcionarios de salud estadounidenses reportaron 53 casos.
El nuevo estudió descubrió que los casos han seguido disparándose, de 476 en 2019 a 756 en 2020, y luego a 1.471 en 2021. Los médicos también han detectado el hongo en la piel de miles de pacientes más, lo que los convierte en un riesgo de transmisión para otras personas.
Muchos de los primeros casos en Estados Unidos fueron infecciones traídas del extranjero, pero ahora la mayoría de las infecciones se propagan dentro del país, señalaron los autores. ___ The Associated Press recibe apoyo para sus coberturas de salud y ciencia de parte del Departamento de Educación Científica del Instituto Médico Howard Hughes. La AP es la única responsable de todo el contenido.